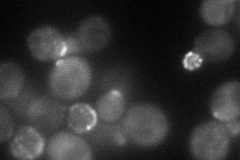
YER114C
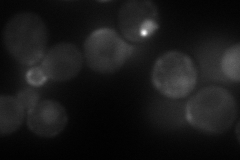
YER114C
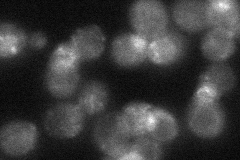
YER114C

View description
Protein implicated in polar growth, functionally redundant with Boi1p; interacts with bud-emergence protein Bem1p; contains an SH3 (src homology 3) domain and a PH (pleckstrin homology) domain
Localization:
Intensity:
Fold change:
Significance:
-
C’ GFP library in SD

bud neckN/A -
N' NOP1pr-GFP in SD
punctate,bud neck66.3254 -
N' TEF2pr-mCherry in SD
punctate,bud neck83.6917 -
N' NATIVEpr-GFP in SD
punctate,bud neck39.6341 -
N' TEF2pr-VC and Cyto-VN in SD

punctate,bud neck43.1046 -
C’ GFP library in SD+DTT

technical problem0N/ANo -
C’ GFP library in SD+H2O2

bud neck45.321.32No -
C’ GFP library in Starvation Media

punctateN/AN/AYes -
C’ GFP library on the background of Pup2-DaMP

bud neck -
C’ GFP library on the background of CCT mutant

bud neck35.97671.05361No
